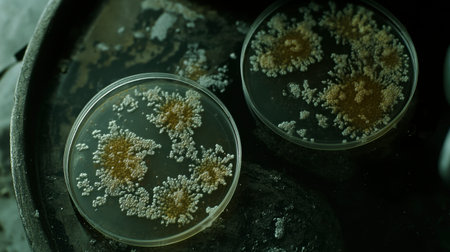
Close-up view of petri dishes displaying fungal growth in a dim laboratory environment. Ideal for science and microbiology themes emphasizing experimentation and research.の素材

素材 - Close-up view of petri dishes displaying fungal growth in a dim laboratory environment. Ideal for science and microbiology themes emphasizing experimentation and research.
作品情報
Close-up view of petri dishes displaying fungal growth in a dim laboratory environment. Ideal for science and microbiology themes emphasizing experimentation and research.
- ID:257419363
- 作品種別:
- 作者名:puttipong songsanket
キーワード
- agar
- analysis
- biology
- biotechnology
- cell
- cells
- contrast
- culture
- dark background
- decay
- education
- environment
- experiment
- fungus
- growth
- habitat
- health
- isolation
- laboratory
- laboratory tools
- medical
- microbes
- microbiology
- microorganism
- moist
- natural
- nature
- nutrient
- observation
- organic
- petri dish
- petri dish lid
- research
- round
- sample
- science
- specimen
- specimen preparation
- study
- surface
- testing
- treatment
- variation
- visual
- visualization
- work
類似作品
panoramic View ...
Seen from the t...
Looking through...
Panoramic view ...
Crowds fill a l...
A stunning view...
Dubrovnik is a ...
Panorama aerial...
Kutahya City pa...
A stunning aeri...
View Of Dubrovn...
View of the Mon...
Top view from t...
Cityscape view ...
Locks on the ca...
View of Lisbon ...
Santarcangelo v...
Panorama Lisbon...
Beautiful sunse...
View many build...
Panoramic view ...
Aerial drone sh...
Rooftops of hou...
A captivating v...
Sunset real est...
Beautiful summe...
Umbral landscap...
Aerial view fro...
Panoramic view ...
Inspirational a...
Female tourist ...
Panorama aerial...
Italy, Rome, Va...
A single, perfe...
Beautiful view ...
A panoramic vie...
The view on Flo...
Railway tracks ...
Aerial view of ...
View from back....
View of Binocul...
Prague, Czech R...
View Of The Red...
A view from a h...
Shot on the 12t...
Old town or cit...
Aerial drone sh...
Travel concept ...
Rome rooftop vi...